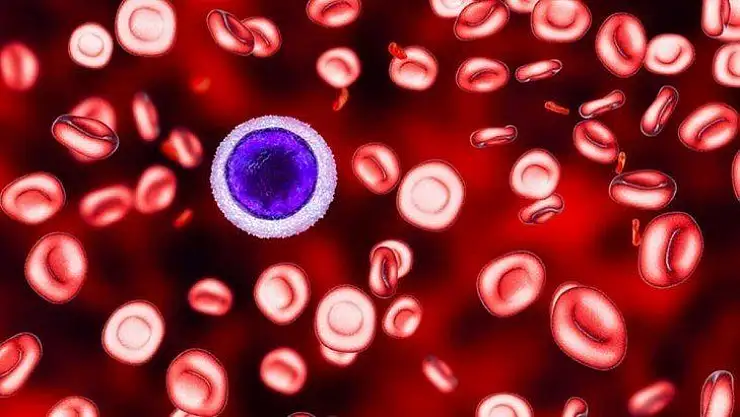

Prof. Dr. Anak: Akdeniz anemisi kök hücreyle tedavi ediliyor
Prof. Dr. Anak: Akdeniz anemisi kök hücreyle tedavi ediliyor

Talaseminin (Akdeniz anemisi) dünyada ve Türkiye’de en sık görülen kalıtsal kan hastalığı olduğunu söyleyen Çocuk Hemotoloji ve Onkoloji Bölüm Başkanı Prof. Dr. Sema Anak, talaseminin kronik hastalık haline geldiğini vurgulayarak kök hücre nakliyle tedavinin mümkün olduğunu dile getirdi.
Medipol Mega Üniversite Hastanesi Çocuk Hemotoloji ve Onkoloji Bölüm Başkanı Prof. Dr. Sema Anak, 8 Mayıs Dünya Talasemi Günü kapsamında halk arasında Akdeniz anemisi olarak da bilinen talasemiye ilişkin bilgi verdi.
Talaseminin dünyada ve Türkiye’de en sık görülen kalıtsal kan hastalığı olduğunu belirten Prof. Dr. Anak, taşıyıcı anne ve babadan gelen genlerle hastalığın ortaya çıktığına dikkat çekti. Prof. Dr. Anak, bu nedenle akraba evliliklerinin sık olduğu ülkelerde talaseminin daha çok görüldüğüne değinerek “Sıtmanın sık olduğu bölgelerde de talasemi daha çok görülüyor” dedi.
“EN AZ 1 MİLYON TAŞIYICI VAR”
Türkiye'deki beta talasemi taşıyıcısı oranının yüzde 2,1 düzeylerinde olduğunu belirten Prof. Dr. Anak, “Özellikle güney-batı bölgelerimizde, Ege, Akdeniz bölgesinde ve Trakya’da sık görülür. Bu bölgelerde sıklık artmakta, yüzde 12'e kadar yükselmektedir. Türkiye'de yaklaşık 1 milyon 400 bin taşıyıcı ve 4 bin 500 talasemi hastası vardır. Beta talasemide, kansızlık belirtileri genellikle doğumda yoktur. Yaşamın 3 ila 6’ncı ayından sonra başlar, yaklaşık ayda bir sürekli kan verilmesini gerektiren ağır bir hastalıktır” diye konuştu.
TALASEMİNİN BELİRTİLERİ
Prof. Dr. Anak, “Bu çocuklar kendileri için gerekli olan hemoglobini (kan düzeyini) yeterli miktarda yapamazlar ve halsizlik, solukluk, iştahsızlık, huzursuzluk, karaciğer ve dalak büyümesi, büyüme-gelişme geriliği ve özellikle yüz, kafa kemiklerindeki anormallikler hastalığa ait ana bulgulardır. Verilen kanların içindeki fazla demir vücuttan atılamaz ve deride, kalp, karaciğer, beyin, endokrin organlarda birikir ve bu organları bozarak kalp yetmezliği, karaciğer yetmezliği, diyabet ve diğer biriktiği bölgelerde sorunlarla gider. Demir vücuttan uzaklaştırılamazsa erken yaşlarda sıralanan organların yetmezliği ile kaybedilirler. Talaseminin sık görüldüğü bölgelerde, aile hikayesi ve akraba evlilikleri de varsa, çocukta erken kansızlık geliştiğinde ve bulgular ortaya çıktıysa gerekli tam kan sayımı, periferik yayma, biyokimya, hemoglobin elektroforezi, genetik testler yapılmalıdır” ifadelerini kullandı.
“KÖK HÜCRE VE KEMİK İLİĞİ NAKLİYLE TEDAVİ MÜMKÜN”
Hastaların 3-4 haftada bir kırmızı kan hücresi almak zorunda olduğuna işaret eden Prof. Dr. Anak, tedavilere ilişkin şu bilgileri paylaştı:
“Sürekli demiri vücuttan atmaya yönelik kelatörleri derialtı, damardan veya ağızdan (en sık kullanım) kullanmak zorundadırlar. Artık dalak alınması çok nadir gerekmektedir. Etkin ve başarılı kan ve demir atıcı tedavilerle artık hastalar 50-60 yaşlarına kadar yaşıyorlar. Talasemi artık kronik bir hastalık haline gelmiştir. Ancak iyileştirici tedavi kök hücre nakli ve son zamanlarda deneysel nitelikte yapılan gen naklidir. Doku grubu uygun özellikle kardeş (taşıyıcı da olabilir) veya bankadan akraba dışı vericilerden çok gecikmeden (3-10 yaş) yapılan nakillerde başarı yüksektir. Başarı alıcı ve verici özelliklerine göre yüzde 60 ila 90 sağ kalım şeklindedir. Vericisi olmayan hastalarda doku grubu uygun verici kardeş IVF yöntemleriyle oluşturulabilir. Aynı yöntemle sağlıklı çocuk sahibi olmak da mümkündür. Nakil sonrası nadiren verici kemik iliği oturmaz veya ret olur; tekrar nakil gerekebilir. Gen nakli hızla gelişmekteyse de halen deneyseldir.”
“LÖSEMİYE DÖNÜŞME RİSKİ YOK”
Talaseminin lösemiye dönüşüm riski olmadığını söyleyen Prof. Dr. Anak, “Talasemi taşıyıcılarının önemli bir kısmı kansızlık sorunu ile karşılaşırlar. Diğer kansızlık nedenleri tedaviyle düzelse de hemoglobin düzeyleri düşüktür. Bu kişilere gereksiz demir verilmesi sakıncalıdır. Folik asit takviyesi yararlı olsa da tartışmalıdır. Bunun dışında yaşa uygun normal beslenme yapılmalıdır” dedi.
Bakmadan Geçme